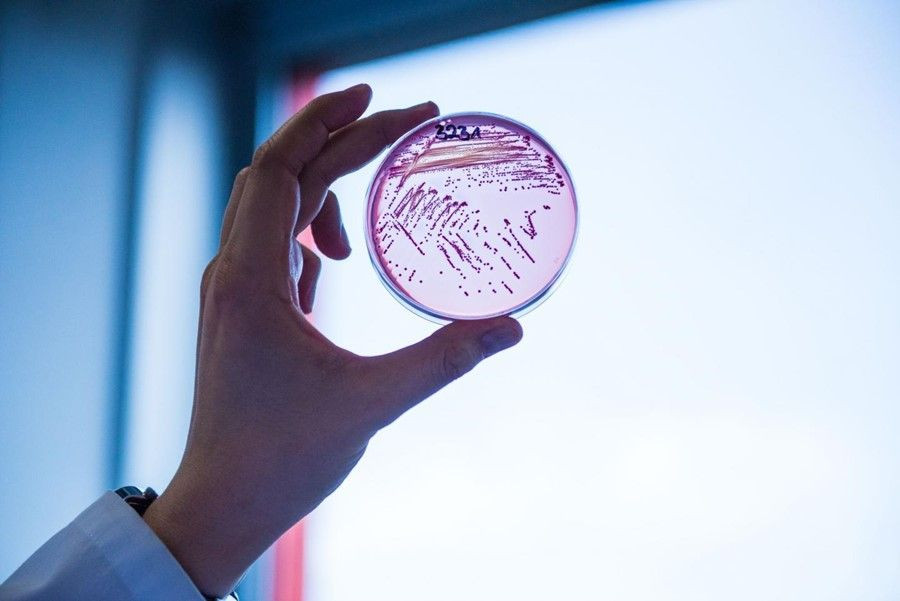

Desarrollan una `E. coli` sintética reprogramada que presenta gran resistencia viral
Investigadores del Laboratorio de Biología Molecular del Consejo de Investigación Médica de Cambridge, en Reino Unido, han desarrollado una bacteria `E. coli` sintética reprogramada que presenta resistencia viral, según publican en la revista `Science`.
Mediante la ingeniería del código genético de una cepa sintética de `E. coli` para incluir varios aminoácidos no estándar, los investigadores hicieron que la bacteria sintética fuera prácticamente invencible a la infección viral. Su trabajo es uno de los primeros en diseñar proteínas utilizando no uno sino varios aminoácidos no canónicos.
"La capacidad de generar proteínas de diseño utilizando múltiples bloques de construcción no naturales desbloqueará innumerables aplicaciones, desde el desarrollo de nuevas clases de bioterapias hasta biomateriales con propiedades innovadoras", escriben en una Perspectiva relacionada Delila Jewel y Abhishek Chatterjee, del Boston College in Chestnut Hill, en Estados Unidos.
En la naturaleza, los sistemas biológicos utilizan 64 codones --un triplete único de nucleótidos-- para codificar y guiar la síntesis templada de proteínas a partir de una colección de 20 aminoácidos canónicos.
Se cree que eliminar ciertos codones y los ARN de transferencia que los leen del genoma y sustituirlos por aminoácidos no canónicos (ncAA) puede permitir la creación de células sintéticas con propiedades que no se encuentran en la biología natural, como potentes resistencias virales y una mayor biosíntesis de nuevas proteínas.
Sin embargo, aunque se han codificado genéticamente cientos de ncAA diferentes en diversos ámbitos de la vida, el enfoque se ha limitado en gran medida a la incorporación de un único ncAA en una cadena polipeptídica.
Aquí, Wesley Robertson y sus colegas demuestran la incorporación específica de múltiples ncAAs distintos en proteínas utilizando una cepa sintética de `E. coli`. Eliminaron los ARN de transferencia y el factor de liberación y crearon células de `E. coli` que no leen varios codones.
Como los virus dependen de la capacidad de la célula huésped para leer todos los codones del genoma viral para reproducirse, las células de `E. coli` modificadas se volvieron completamente resistentes a una amplia variedad de virus. Además, los autores reasignaron cada uno de estos codones a tres ncAA distintos y demostraron que la síntesis eficiente de proteínas de diseño es, efectivamente, posible.




























Sé el primero en comentar